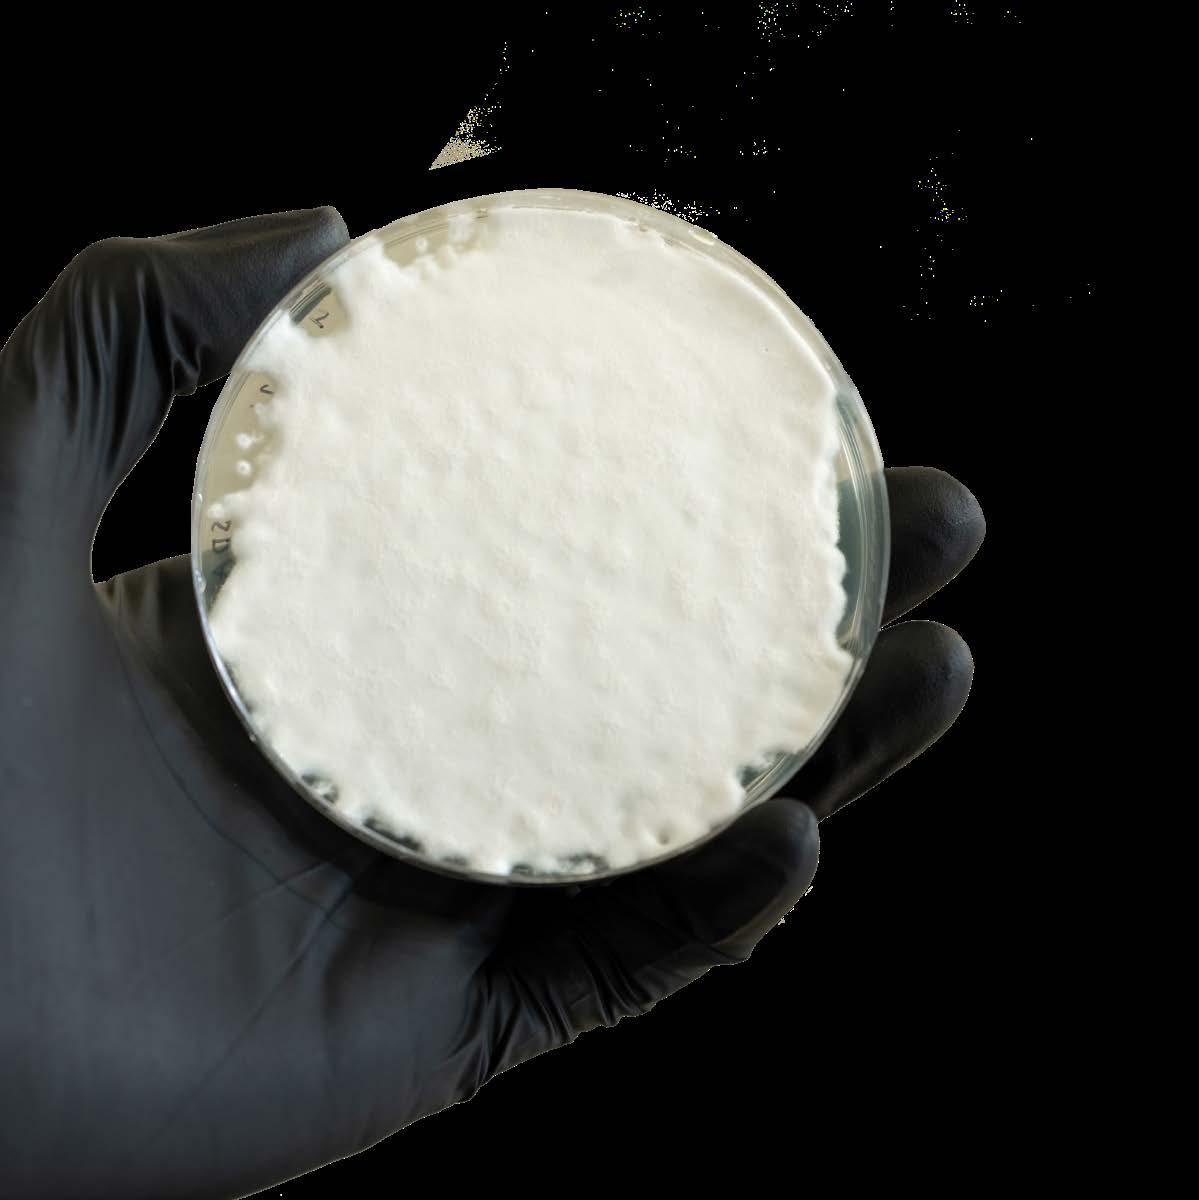

KENNESAW STATE UNIVERSITY


![]()
KENNESAW STATE UNIVERSITY



When you come to KSU, you will discover a community where your past experiences and future aspirations unite, molding an educational journey uniquely shaped to bring your education to the next level. As you settle into The Nest, you will transition into an inclusive and accessible environment where you can seamlessly integrate your previous studies into one of KSU’s 190+ programs, find your passion, and thrive as an Owl.
At KSU, you will find endless opportunities to build new relationships, find new communities, and explore new interests. Whether your journey here is to expand your degree options or to gain different experiences, you will learn to embrace your individuality, unwrap your true potential, and unveil your authentic self in a place where anything is possible.




For more than 60 years, we’ve set the bar high for universities across the state, from being the first to have a female president to holding one of the top spots in size and reputation. Now you can be a part of that history, too.

48,500+ 2,700+ STUDENTS TRANSFERRED TO KENNESAW STATE
ENROLLED STUDENTS

OUR STUDENTS COME TO US FROM
70 COUNTRIES
42 U.S. STATES
111 GEORGIA COUNTIES

Nestled in the suburbs of Metro Atlanta, our campuses provide the perfect balance, away from the hustle and bustle of the big city yet close enough to experience its opportunities. And when you’re a part of Owl Nation, stepping onto campus feels like coming home — a place where discovery and innovation thrive, where fond memories are created each day, and where potential meets possibility. Learn more about living on campus at ksuhub.com/KSUHousing.

With more than 80 undergraduate degree programs, you’ll find endless opportunities to expand your horizons and embrace the spirit of innovation. Our top-ranked programs and collaborative academic community will inspire you to make intentional decisions about your future, equipping you with the skills to positively impact the world. ksuhub.com/majors
Accounting l
Anthropology l
Applied Science in Information Technology n
Architecture n
Art l
Art History l
Asian Studies l
Biochemistry l
Biology l
Black Studies l
Chemistry l
Computer Game Design & Development n
Computer Science n
Construction Management n
Criminal Justice l
Cybersecurity l
Dance l
Data Science & Analytics n
Digital Animation l
Economics l
Education, Art l
Education, Early Childhood
Birth through Kindergarten l
Education, Elementary l
Education, English l
Education, History l
Education, Middle Grades l
Education, Music l
Education, Secondary l
Electrical Engineering Technology n
Engineering n
Engineering, Civil n
Engineering, Computer n
Engineering, Construction n
Engineering, Electrical n
Engineering, Environmental n
Engineering, Industrial & Systems n
Engineering, Mechanical n
Engineering, Mechatronics n
Engineering, Software n
English l
Entrepreneurship l
DEGREE & CERTIFICATE PROGRAMS IN 11 COLLEGES
DOCTORAL, MASTER’S, AND GRADUATE-LEVEL PROGRAMS

Environmental Science l
Exercise Science l
Finance l
Geography l
Geospatial Sciences l
Health & Physical Activity Leadership l
History l
Hospitality Management l
Human Services l
Industrial Engineering Technology n
Information Security & Assurance l
Information Systems l
Information Technology n
Integrated Health Science l
Interactive Design l
Interdisciplinary Studies l
International Affairs l
International Business l
Journalism & Emerging Media l
Learning, Design, & Technology l
Management l

Marketing l Mathematics n
Mechanical Engineering Technology n
Media & Entertainment l
Modern Language & Culture l
Music l
Nursing l
Organizational & Professional
Communication l
Philosophy l Physics n
Political Science l
Professional Sales l
Psychology l
Public Health l
Public Relations l
Sociology l
Sport Management l
Technical Communication l
Theatre & Performance Studies l KEY l Kennesaw Campus n Marietta Campus

ACCELERATED BACHELOR’S TO MASTER’S PROGRAMS
Highly motivated? Consider accelerating your path toward a master’s degree. Double Owl Pathways provide the opportunity to obtain your undergraduate and graduate degrees faster and at a significantly lower cost than pursuing each degree independently. ksuhub.com/doubleowl


Embarking on a graduate degree program is an opportunity to aspire higher both academically and professionally. Through advanced coursework, research, and specialized training, you will delve deeper into your chosen field, gaining invaluable expertise and insight. ksuhub.com/graduate

You will become engaged in every aspect of your academic journey at KSU. Here, academic success services are not just resources — they are pathways to your growth and achievement. With dedicated advisors supporting you every step of the way, you will navigate challenges with confidence, set ambitious goals, and achieve academic excellence. Kennesaw State gives you the academic resources to reach your fullest potential.

KSU believes in the power of research and the importance of providing you with program opportunities that are relevant to the needs of tomorrow. KSU provides real-world resources and mentorship to fuel your desire to learn, developing skills that will shape your professional future. ksuhub.com/research
Transfer students with less than 70 credit hours and a transfer GPA of 3.5 or higher are invited to apply for the KSU Journey Honors College.

Ellie Foster, a member of the President’s Emerging Global Scholars (PEGS) Program, has participated in three study abroad programs––Costa Rica, Italy, and South Korea!

When you join the Keeping Sights Upward Journey Honors College, you join students from across all disciplines that share the commitment to make the most of their undergraduate experience. Our innovative curriculum focuses on experiential learning while promoting leadership, professional development, and civic and social engagement — all designed to amplify your individual pathway and provide a community that extends beyond stellar academics. ksuhub.com/honors
Honors students are eligible for both need- and merit-based honors scholarships ranging from $1,000 to $5,000 per year.
Smaller seminar-style classes and specialized advising make for a supportive experience.


BECOME GLOBAL
KSU believes that changing the world starts by seeing it. Your unique perspective, honed through your studies abroad, sets you apart in an increasingly competitive job market. But beyond professional and academic growth, studying abroad is about personal transformation. Once you see the world through the eyes of people who think and feel differently than you do, you can build understanding and relationships that impact the world. Being global is about discovering who you are in the context of a larger world, forging connections that transcend borders, and becoming a catalyst for positive change.
ksuhub.com/studyabroad

BE READY FOR

The Wellstar School of Nursing is the largest nursing program in north Georgia, and our graduates consistently outperform the national average on the state licensing exam.

lifelong achievement. Our most successful students are those who take advantage of opportunities beyond the classroom to develop their skills. Whether it’s through internships, networking events, or workshops focused on career competencies, each experience you engage in is a stepping stone toward building a solid foundation for your future, ultimately leading to your dream career. ksuhub.com/careers



You will find many opportunities during your time at KSU to be a part of internships and co-ops. These resume-building experiences are a valuable stepping block from academia to the professional world, providing you with the skills, experience, and connections that are necessary for a successful career.
29,613 INTERNSHIPS, CO-OPS, AND FULL-TIME JOBS ON THE KSU JOB BOARD
863
10,842


COMPANIES ATTENDED KSU CAREER FAIRS
COMPANIES RECRUITED STUDENTS AND ALUMNI
Source: 2023 CPD Job Fair Data

KSU service-learning allows for real-world experience by allowing you to take concepts learned in the classroom and bring them into community service projects. These assignments allow you to utilize a variety of skills, including leadership, communication, problem-solving, and teamwork.

YOUR DREAM CAREER AWAITS
From Fortune 500s and 1000s to more than 700 startups, Atlanta is where inventive minds can make their mark in a top tech market.
YOUR MONEY WILL GO FURTHER
Your hard work will go further in Atlanta because it is considered to be one of the most affordable major metro cities in the United States.
BLAZE YOUR OWN TRAIL
Atlanta is ranked a top rising startup city in the U.S. by Forbes and is ranked the #4 metro area for women-owned businesses by American Express.
Source: chooseatl.com
At KSU, we believe in empowering you with the tools and knowledge needed to thrive in the workforce without burdening your financial future. With a focus on practical learning and responsible financial decisions, you can graduate equipped with the skills employers value, without drowning in student debt. We make college degrees a reality for thousands of students each year, and we’d like to add






While earning her associate’s degree in cosmetology, Lexie found herself interested in the chemistry behind the colors used in hair dye. This interest led her from the salon floor to KSU to seek a chemistry degree and complete award-winning research Learn more by visiting ksuhub.com/Lexie.


FAFSA stands for the Free Application for Federal Student Aid. It’s an application that uses your tax information (and, if you are a dependent student, tax information from your parent[s]) to determine your eligibility for various federal financial aid, including grants, loans, federal work-study programs, and more. If you think there’s a chance you will need financial aid to afford college, you should file a FAFSA. ksuhub.com/FAFSA
If you are a Georgia resident who has met academic achievement standards, you may be considered for the HOPE or Zell Miller Scholarships. These merit-based scholarships are available to students who are residents in the state of Georgia and are enrolled in an undergraduate degree-seeking program. You can find a full list of requirements and application at gafutures.org.
KSU makes the scholarship application process painless with a one-stop resource for students to apply for internal and external scholarships. ScholarshipUniverse functions like a matching service: You create a profile outlining your academic achievements and goals, organizational affiliations, and your desired course of study, and the website matches you with potential scholarships that might be a good fit. ksuhub.com/scholarships
If you are an out-of-state student with an exceptional GPA, you may be eligible for an out-of-state tuition waiver. ksuhub.com/waiver



Imagine a place where every dream, every hope, and every passion is not just welcomed but celebrated — that’s what it means to be a part of Owl Nation. With over 2,000 programs and events occuring each semester, the possibilities for involvement are endless. No matter where you are coming from, we have the resources to help you transfer to KSU and enjoy success in and out of the classroom. Take advantage of our array of academic services and make new friends by getting involved. ksuhub.com/involvement KSU provides various peer-to-peer mentor programs, including the Odyssey Peer Mentoring Program for first-year and transfer students to help with the college transition.
Our database lists courses from other institutions and the KSU equivalents to help you determine how your credits can transfer to KSU. ksuhub.com/owltransfer

To be considered for transfer admission, you must have:
• graduated from high school,
• earned 30 semester hours (or 50 quarter hours) of college credit, and
• earned the equivalent of English 1101 and Math 1101 or higher with a grade of C or higher in each.
Students can apply to KSU before they have received an associate’s degree. Applying one semester before your planned entry term will ease your transition and may provide you with an earlier decision. It will also give you plenty of time to pursue financial aid opportunities.
Apply online via GAfutures by visiting ksuhub.com/apply. Submit your application and the $40 application fee by the deadline of your desired semester of entry. Official transcript(s) from high school(s) and/or college(s) must be sent directly from the institution either electronically to ksuadmit@kennesaw.edu or mailed to the address below. AP and CLEP scores must be sent electronically directly from College Board to KSU.
Hard copies of transcripts can be mailed directly from the institution to:
Kennesaw State University Office of Undergraduate Admissions
3391 Town Point Drive, MD 9111 Suite 1000 Kennesaw, GA 30144
Students are typically notified with a decision within 2–4 weeks from the completion of their application.
• Fall and Summer applications open August 1.
• Spring applications open April 1.
• Applications are downloaded by KSU Admissions approximately 48 hours after submission.
• Once a transcript has been released to KSU, allow 7-10 business days for download and processing by KSU Admissions.
• Transfer students admitted for the Fall and/or Summer semesters will begin registering for classes at the end of March.
• Transfer students admitted for the Spring semester will begin registering for classes at the end of October.
All transfer applicants must be in good academic standing at their home institution. Transfer applicants must have a minimum cumulative 2.0 GPA to be considered for admission. Architecture Degree transfer applicants must have a minimum cumulative 2.5 GPA. KSU calculates cumulative GPA based on all attempted college coursework from all colleges attended.
Once you are accepted, your transcripts will be evaluated for relevant transfer credits for your selected degree program. After you receive your official transfer evaluation confirmation email, you’ll meet with your academic advisor to plan your course of study. ksuhub.com/transfer

KSU has teamed up with other colleges in Georgia to launch the LINK Program, making it easier for students to transfer and succeed in KSU’s academic community. This program connects KSU with various institutions to offer smooth educational experiences, from undergrad to grad school, helping students reach their goals. Each partnership is unique; for example, one partnership offers a technical college student the opportunity to transfer their associate’s degree credits to KSU, and another partnership provides a fast track from an undergraduate to a master’s degree by transferring final-year coursework. If you’re interested, visit our website to view current LINK pathways and next steps to get started.
ksuhub.com/LINK


Kennesaw State University’s Marietta Campus is expanding. Construction on the Interdisciplinary STEM Building is set to be completed Fall 2025. The approximately 70,000-square-foot building will advance teaching in science, technology, engineering and mathematics and foster collaboration among researchers across multiple disciplines.

But by spending time here, you’ll really get a feel for what academic and social life are like at KSU. More than just a visit, it’s a chance to see our campus culture firsthand and learn more about the supportive campus community waiting for you. We invite you to continue your academic journey and discover excellence at Kennesaw State. ksuhub.com/visit



Led by a student tour guide, the campus tour highlights academic programs, housing, dining, and admissions. You can choose to visit both the Kennesaw and Marietta Campuses or the campus that houses your academic program. ksuhub.com/visit

These comprehensive Saturday events occur four times per semester to introduce prospective students and their families to Owl Nation. You’ll experience what it’s like to be a KSU student by learning about academic programs, housing, dining, financial aid, and more. ksuhub.com/OpenHouse

Join our transfer admissions counselors for virtual sessions that dive into specific information about the transfer process, credit evaluation, and the next steps after admissions. ksuhub.com/VisitKSU

©2024-2025 KENNESAW STATE UNIVERSITY
Statistical information and offerings presented are subject to change. Please visit kennesaw.edu for the most up-to-date information.
KSU IS DEDICATED TO SAFETY.
The KSU Annual Security and Fire Safety Report is available for review. The report contains campus crime statistics, safety programs, and KSU policies. You may view the information by visiting ksuhub.com/safety or request a printed copy by emailing escomm@kennesaw.edu.